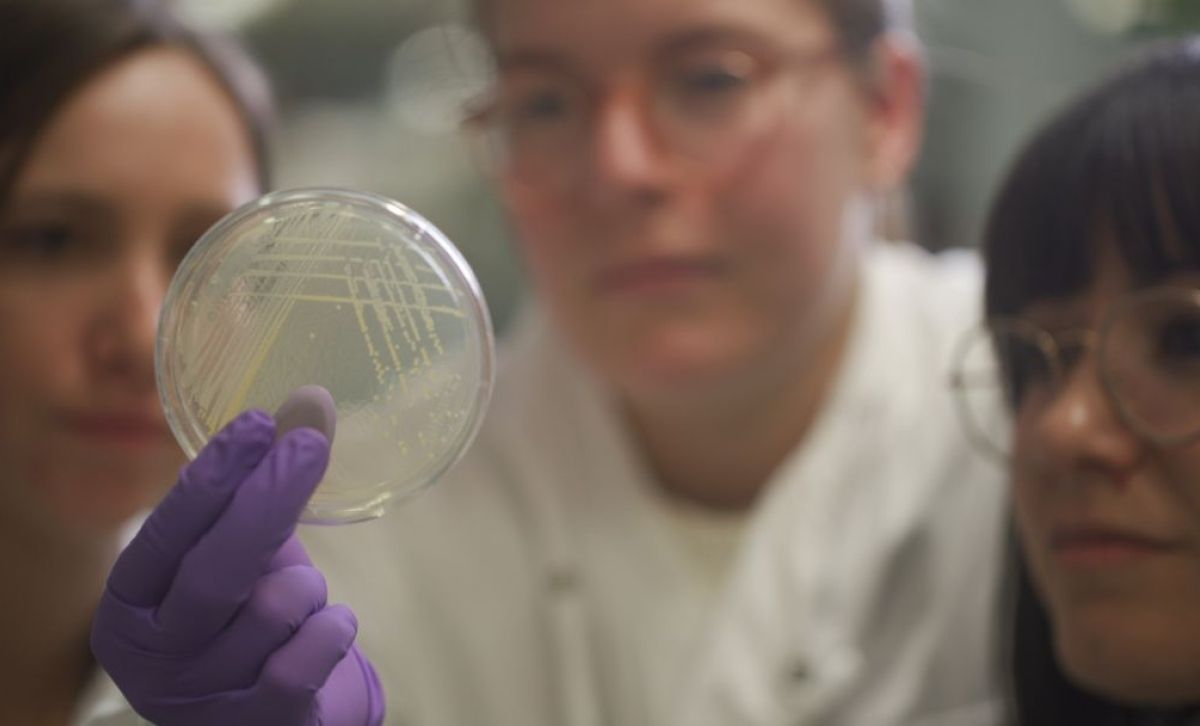

Share the page
Sign up for our newsletters
Join our mailing lists to receive updates about our latest research and to hear about our free public events and exhibitions. If you would like to find out more about how we manage your personal information please see our privacy policy.